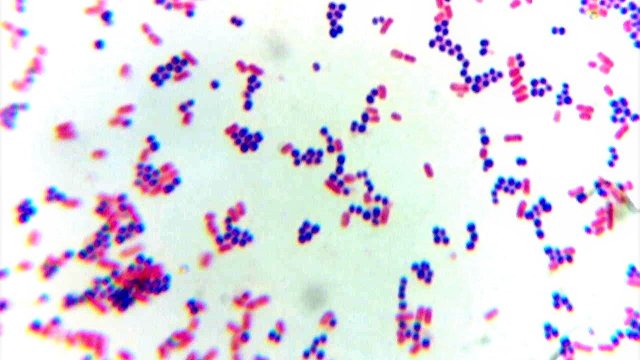

Baccalauréat STL spécialité Biotechnologies
2 articles
2nd - Option Biotechnologies
L’option "Biotechnologies" est proposée aux élèves de seconde dans plusieurs établissements scolaires. Elle permet de découvrir les domaines des...
Publié le 04/12/2024

STL Biotechnologies, une voie d’excellence vers les...
présentation de la filière STL Biotechnologies
Publié le 08/11/2024